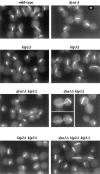
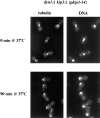

Mitotic spindle positioning in Saccharomyces cerevisiae is accomplished by antagonistically acting microtubule motor proteins
- PMID: 9281582
- PMCID: PMC2136752
- DOI: 10.1083/jcb.138.5.1041
Mitotic spindle positioning in Saccharomyces cerevisiae is accomplished by antagonistically acting microtubule motor proteins
Abstract
Proper positioning of the mitotic spindle is often essential for cell division and differentiation processes. The asymmetric cell division characteristic of budding yeast, Saccharomyces cerevisiae, requires that the spindle be positioned at the mother-bud neck and oriented along the mother-bud axis. The single dynein motor encoded by the S. cerevisiae genome performs an important but nonessential spindle-positioning role. We demonstrate that kinesin-related Kip3p makes a major contribution to spindle positioning in the absence of dynein. The elimination of Kip3p function in dyn1Delta cells severely compromised spindle movement to the mother-bud neck. In dyn1Delta cells that had completed positioning, elimination of Kip3p function caused spindles to mislocalize to distal positions in mother cell bodies. We also demonstrate that the spindle-positioning defects exhibited by dyn1 kip3 cells are caused, to a large extent, by the actions of kinesin- related Kip2p. Microtubules in kip2Delta cells were shorter and more sensitive to benomyl than wild-type, in contrast to the longer and benomyl-resistant microtubules found in dyn1Delta and kip3Delta cells. Most significantly, the deletion of KIP2 greatly suppressed the spindle localization defect and slow growth exhibited by dyn1 kip3 cells. Likewise, induced expression of KIP2 caused spindles to mislocalize in cells deficient for dynein and Kip3p. Our findings indicate that Kip2p participates in normal spindle positioning but antagonizes a positioning mechanism acting in dyn1 kip3 cells. The observation that deletion of KIP2 could also suppress the inviability of dyn1Delta kar3Delta cells suggests that kinesin-related Kar3p also contributes to spindle positioning.
Figures

Comment in
-
Motoring to the finish: kinesin and dynein work together to orient the yeast mitotic spindle.J Cell Biol. 1997 Sep 8;138(5):957-60. doi: 10.1083/jcb.138.5.957. J Cell Biol. 1997. PMID: 9281575 Free PMC article. Review. No abstract available.
References
-
- Book KJ, Howard R, Morest DK. Direct observation in vitro of how neuroblasts migrate: medulla and cochleovestibular ganglion of the chick embryo. Exp Neurol. 1991;111:228–243. - PubMed
-
- Book KJ, Morest DK. Migration of neuroblasts by perikaryal translocation: role of cellular elongation and axonal outgrowth in the acoustic nuclei of the chick embryo medulla. J Comp Neurol. 1990;297:55–76. - PubMed
-
- Chenn A, McConnell SK. Cleavage orientation and the asymmetric inheritance of Notch1 immunoreactivity in mammalian neurogenesis. Cell. 1995;82:631–641. - PubMed
Publication types
MeSH terms
Substances
Grants and funding
LinkOut - more resources
Full Text Sources
Molecular Biology Databases

